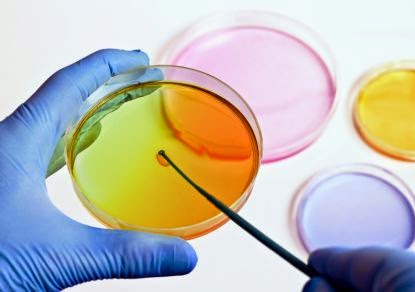

Израиль возглавил рейтинг Всемирной организации по защите интеллектуальной собственности за прошлый год в номинации "Своевременная подача международных патентных заявок". Об этом сообщает портал Ynet.
В противовес бытующему мнению, что израильтяне многие вещи делают с ленцой, не торопясь, с левантийским характером, наша страна разделила вместе с Японией статус государства, где прекрасно понимают и знают, как защищать интеллектуальную собственность на международном уровне.
Как видно из отчета Всемирной организации, 99,7% поданных израильтянами заявок на оформление патента проходят бюрократическую процедуру всего за четыре недели. Оставшиеся 0,3% относятся к патентам, которые должны пройти проверку в Министерстве обороны и структурах безопасности Израиля.
Израиль занимает ведущее место в мире по такому показателю как рост числа заявок на патенты. По данным за 2012 год, Израиль увеличил число заявок на 24%. Для сравнения, занимающий второе место Китай увеличил число заявок на 15%. США (третье место в этой номинации) — на 11%.
Израиль также совершил качественный скачок в таком показателе как патенты в области глобальных цифровых коммуникаций и медицинской техники. Наша страна входит в тройку ведущих государств в этом отношении: с 2009 по 2013 год израильтяне подали 1470 заявок на оформление патентов в этих областях, уступая только Голландии и Великобритании.
Израиль занимает пятое место в рейтинге стран в отношении количества исследований, разработок и подачи заявок на патентирование учеными университетов или сотрудниками государственных научно-исследовательских учреждений.
Согласно отчету Всемирной организации, в прошлом году израильтяне подали 6148 заявок на патенты в разных областях. 3698 заявки были приняты и оформлены как патенты.
Источник: 9tv.co.il
Комментариев нет:
Отправить комментарий